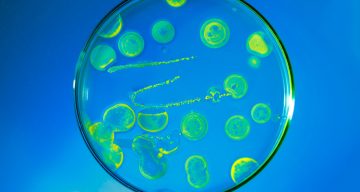

Prevent Summer Learning Loss with Science Activities
Looking for fun summer activities to prevent summer break learning loss? Try these 5 activities that are perfect for budding scientists, technologists, engineers or mathematicians!
Green Thumb Science Project: the pH of Soil
Explore the outdoors and grow new plants in your garden this summer. This project will teach your child about the effects of pH on plants, and how soil conditions influence growth.
Create Your Own Meteorology Weather Center
Make a barometer, a weather vane, and a thermometer to create your own weather center! Use this science fair project to create your own at-home meteorology study.
Do People Remember Better in Color?
Using just a few coloring book pages, send your little scientist out to gather data. This psychology experiment tests whether people recall details better when color is involved.
Create Hydropower Energy
Create your own water wheel and learn about sustainable energy with this activity that’s meant for the classroom but is easily modified for home.
Grow Bacteria in a Petri Dish
Kids will love seeing the bacteria from their mouths grow in this extra-gross science experiment.